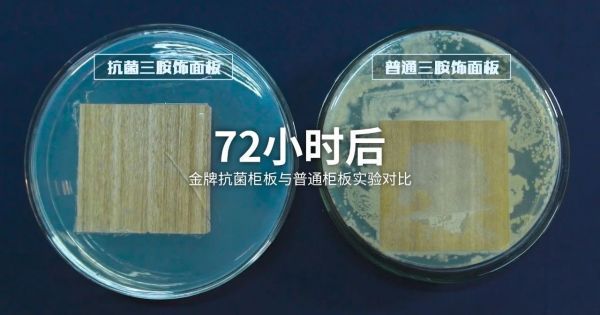

中科院朱美芳院士:中国人的衣食住行将快速步入抗菌时代
国际卫生组织经过调查,证实了这个问题:一个人77%行为(生活方式、社会及环境因素)影响着身体的健康,而遗传及医疗因素仅占了23%。
国家发布《中国居民营养与慢性病状况报告(2015)》、印发《“健康中国2030”规划纲要》,目的是为解决影响人们健康的突出问题,推动全民健身和全民健康深度融合,加强食安建设,努力减少公共安全事件对人们健康的威胁;从而推动全民健康。

官方出台政策推动全民健康,众多企业也追随支持,主动创新,采取措施布局大健康产业,推动健康家居生活。
01食安问题是健康的关键
食安问题要从预防“病从口入”着手,厨居、家电产品是其中的关键环节。
与2003年非典相比较,新冠给厨居、家电行业带来了更深远影响;人们的健康意识被拔高,厨卫、家电制品的健康卖点已经从“亮点”到“刚需”转变;这个深入、长远的变化,将推动两个行业的迭代与升级。
疫情后,企业不再仅是产品供给者,在原有问题被迅速放大时,如何让产品和服务适合当下消费需求,才是企业要全力解答的核心命题,真正竞争力在此时被突显出来。
金牌厨柜于别人之前,推出全系统抗菌厨柜新品,应用银抗菌材料解决厨房厨柜、家电、水槽、台面等“细菌重灾区”问题,一体化的抗菌厨居产品,为人们的食安提供了安全保障,将成为引领厨柜行业升级的趋势。
▲ 金牌厨柜抗菌柜面板将成为产品标配

▲ 金牌厨柜99.99%抗菌的自清洁石英石台面
解决食安问题的抗菌厨柜全面解决方案,可以点击链接https://a.eqxiu.com/s/iOuByB9s?bt=yxy参观,会有更全面、更透彻的理解。
用创新技术打造健康好产品,不仅可提升竞争力,还可让品牌富有吸引力。以人们关注“吃”得健康的问题为着力点,抢占大健康赛道,将发展战略转向大健康,聚焦“健康家居生活”,必将逐步走出品牌的差异化之路。
厨居、家电制品健康了,更能提高食安等级,解决“病从口入”问题,预防慢性病等疾病的出现,让人们的吃得健康,生活健康;企业也能走得更远。
02衣食住行的全面抗菌
正如中国科学院院士朱美芳所说:“衣食住行全面抗菌时代已经不远了,安全、无毒、对环境无污染的抗菌材料将很快被应用到生活方方面面。”

▲中科院院士、晋大专家委员会主任朱美芳教授在“抗菌厨房,健康升级”趋势发布会进行分享
食安问题需要尽快解决,穿得健康、用得健康、住得健康也同样已被提上日程。企业要紧抓时间及关键点,运用全面、系统化的抗菌健康产品方案,在下一个消费市场风口来临前站稳脚跟。
就目前的阶段来看,以下这些品牌表现相对出色:
★ 小米首推行业内99%抗菌的双面银抗菌手机壳抢占市场,引领手机行业服务的升级;
★ 金牌厨柜首推抗菌健康厨居全系统解决方案,用无机抗菌技术,达到99%抗菌,预防接触感染,解决食安问题;
★ 吉利汽车投入3.7亿元,启动抗菌防病毒“全方位健康汽车”研发,力拓汽车行业转向生态系统升级;
★ 格力快速推出可杀灭新冠病毒空气净化器,采用H13级别强效过滤网技术及恒效净化技术,可对病毒进行杀、滤、消三重净化;
……
创新是提升产品核心竞争力的唯一道路,市场对健康的需求不会是昙花一现,在未来的竞争格局中,“健康”肯定是绕不过去的关键词,其市场潜力巨大。这些企业可以说争当了各行业的“第一”,不仅前瞻性布局大健康产业,更是真正理解了什么是抗菌健康,并着手打造一个完整、系统的健康产品解决方案,真正的实现健康升级。

有了先行企业大力创新策略的引领,再加上使用“对”的抗菌材料,相信衣食住行,将很快步入抗菌时代,人们将拥有一个更加全面的健康环境,可极大避免公共卫生安全事件发生时造成的大规模伤害。
03“中国创造”创健康时代
疫情的发生,企业的推动,衣食住行将快速步入抗菌时代。
解决衣食住行的健康问题需要全系统的健康产品。全品类的抗菌解决方案,则将这个复杂问题简单化。
晋大科技提供自主研发、世界先进水平的无机抗菌材料,更可为产品打造定制化的全品类抗菌解决方案。从提供高性能原材料,到应用、开发再到上市的整套方案,具备国内外抗菌企业无法比拟的服务优势;解决企业自开发难题及研发短缺问题,协助企业打破竞争格局,快速抢占市场。

中国经济学家厉以宁曾说,中国的产品不能以“中国制造”为限,而应当努力在某些关键性行业和产品上以“中国创造”代替“中国制造”。我国无机抗菌材料技术已然成熟,并实现了国产化,材料稳定、安全可媲美国际先进水平,可成为各行各业产品创新升级的首选。

全品类抗菌解决方案,为产品建立全面、系统化的抗菌应用方案,相信衣食住行的各行各业将很快会有更多的“第一”冒头,中国的健康创造品牌也将更快的为人们健康生活服务。
网址:中科院朱美芳院士:中国人的衣食住行将快速步入抗菌时代 https://c.jiaju82.com/news-view-id-704194.html

